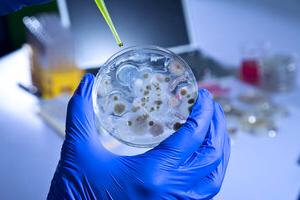
микробиология

Цель: совершенствование у слушателей профессиональных компетенций, необходимых для выполнения профессиональной деятельности в сфере микробиологии.
Категория слушателей: лица, имеющие высшее или среднее профессиональное образование.
Форма обучения: очная, очно-заочная, заочная с применением ДОТ.
Режим обучения: не более 8-ми академ. часов в день.
Информация о курсе
- Организатор:
- Единый Центр Дополнительного Профессионального Образования, г. Москва
- Тип курса:
- Повышение квалификации
- Название курса:
- Курс микробиология
- Выдаваемый документ:
- Удостоверение о повышении квалификации установленного гос. требованиями образца.
- Форма обучения:
- Заочная (дистанционная), очная
- Начало обучения:
- Любой рабочий день
Получить информацию о курсе: микробиология
Учебный план по курсу микробиология
| № | Наименование дисциплины | 72 ак.ч. | 144 ак.ч. | Оценка |
| 1 | Правовые основы деятельности в сфере микробиологии | 4 | 8 | Нет |
| 2 | Общая микробиология | 4 | 8 | Нет |
| 3 | Основы биохимии, санитарии и гигиены | 8 | 16 | Нет |
| 4 | Техническое обеспечение микробиологических работ | 6 | 12 | Нет |
| 5 | Выполнение микробиологических работ | 6 | 12 | Нет |
| 6 | Основы гидробиологии, ихтиологии и ихтиопатологии | 8 | 20 | Зачет |
| 7 | Основы эпизоотологии и патологии гидробионов, санитарной микробиологии | 8 | 16 | Нет |
| 8 | Основы эпидемиологии | 8 | 16 | Нет |
| 9 | Сельскохозяйственная микробиология | 8 | 16 | Нет |
| 10 | Экономика АПК | 8 | 16 | Нет |
| 11 | Итоговая аттестация | 4 | 4 | Зачет |
Использование, воспроизведение и распространение данного объекта интеллектуальной собственности (учебного плана) без согласия правообладателя преследуется по закону.
Выдаваемые документы выписываются и регистрируются в Москве, признаются на всей территории РФ и в других странах

Доступность
образования
Форма обучения с применением дистанционных образовательных технологий через Интернет или очно в группах.

В соответствии
с гос. стандартами
Получаете удостоверение о повышении квалификации, соответствующее установленному образцу.

Выбор даты
обучения
Вы можете начать обучение в течение 3х дней с момента поступления оплаты в любой удобный день.

Доставка документов
по России
После согласования документы направляются курьером или почтой с трек номером в течение 2-3 дней.
Курсы повышения квалификации по лабораторному делу, стоимость и сроки обучения.
Программа обучения по курсу микробиология может иметь несколько вариантов продолжительности обучения в академических часах.
Повышение квалификации по лабораторному делу может быть в стандартном режиме обучения и в ускоренном.
Выберите наиболее подходящий курс для лаборантов в списке на сайте или позвоните по телефону.
Стоимость программы обучения курса по лабораторному делу зависит от выбранного количества часов и режима обучения.
Оставьте запрос информации о курсе в форме. С Вами свяжутся из приемной комиссии и подробно расскажут о возможных вариантах обучения!
Мы принимаем оплату за обучение: Банковские карты, онлайн переводы, электронные деньги, наличные в кассах партнеров, Яндекс Касса.





Процесс обучения
Поступление
Поступить и приступить к обучению можно в любой день!
Поступить на обучение может любой желающий, имеющий среднее профессиональное или высшее образование, а также студент старших курсов. Для начала обучения необходимо отправить заявку на обучение (выше на странице). С Вами свяжутся специалисты по сопровождению учебного процесса, ответят на все вопросы. Далее методический отдел утвердит возможность обучения и после этого мы направим Вам договор и счет. Далее Вам необходимо произвести оплату по счету в банке или в по реквизитам в платежной системе онлайн-банка. Все готово! Вы можете приступать к обучению!
Для поступления требуются в электронном (скан или фото) виде следующие документы:
- заявка и договор об обучении
- копия документа об образовании или справка об обучении (для студентов)
- документ о смене имени, отчества или фамилии (если фамилия, имя или отчество в заявке и дипломе не совпадают)
- для медицинских работников - интернатура, ординатура, дипломы о профессиональной переподготовке, крайний сертификат специалиста (при наличии)
Обучение
В процессе обучения у вас будет открыт доступ на учебный портал, где будут находиться все необходимые методические и учебные материалы. Вы сможете их изучать в онлайн режиме, посредством личного кабинета или скачать к себе на компьютер или мобильный телефон.
Все лекции представлены в PDF-формате, что очень удобно, ведь нет необходимости устанавливать дополнительные программы.
После завершения изучения учебных материалов, Вам необходимо пройти итоговое тестирование. Тестирование Вы можете пройти несколько раз, Вам будет предоставлено как минимум 3 попытки. Дополнительная плата во время обучения не взимается!
После успешной сдачи итогового тестирования Вы получите удостоверение о повышении квалификации.
Выдача документов
После завершения обучения оригиналы документов Вы можете получить лично (забрать у нас в офисе) или мы направим Вам заказным письмом или курьерской службой. Адрес и форма получения оригиналов для направления документов указывается в заявке на обучение.
Наши удостоверения и сертификаты оформляются в бумажном виде на бланках строгой отчётности с несколькими степенями защиты.
Вместе с удостоверением выдаем договор и акт в бумажном виде.
В соответствии с законом об Образовании в РФ, удостоверение о повышении квалификации может быть выдано слушателям, имеющим высшее или среднее профессиональное образование. Если слушатель не имеет такого образования, то ему мы можем выдать свидетельство о доп. образовании (а после получении среднего профессионального или высшего образования слушателю будет выдано удостоверение о повышении квалификации).
Документы оформляются от 1 до 2 рабочих дней.
Государственная лицензия, заключения и сертификаты
Единый Центр Дополнительного Профессионального Образования имеет государственную лицензию на образовательную деятельность №038734.
Лицензия выдана Департаментом образования города Москвы и включена в реестр Рособрнадзора.
Вы можете быстро проверить лицензию на сайте Рособрнадзора.
Проверить